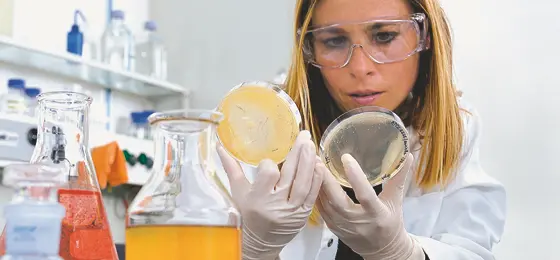

Marie Heim-Vögtlin: 42 grants awarded to promising women researchers in 2016
In December 2016, the SNSF awarded 42 Marie Heim-Vögtlin (MHV) grants to highly qualified women researchers who had to interrupt or reduce their scientific activities due to family commitments.
The 42 new grantees will begin or continue their research activities in 12 Swiss higher education institutions and research institutes. Postdoctoral researchers received 83% of the grants and doctoral students 17%. A total amount of 8.7 million Swiss francs was allocated.
By financing a research project for up to two years, the MHV scheme facilitates the integration of women researchers in academia and allows more women with family commitments to pursue a scientific career. The SNSF relies on the host institutions to contribute to the long-term success of the scheme by committing themselves to providing further financial support following the expiry of the MHV grant.
- Marie Heim-Vögtlin grants: results of the 2016 call (PDF) (PDF)
- Marie Heim-Vögtlin (MHV)